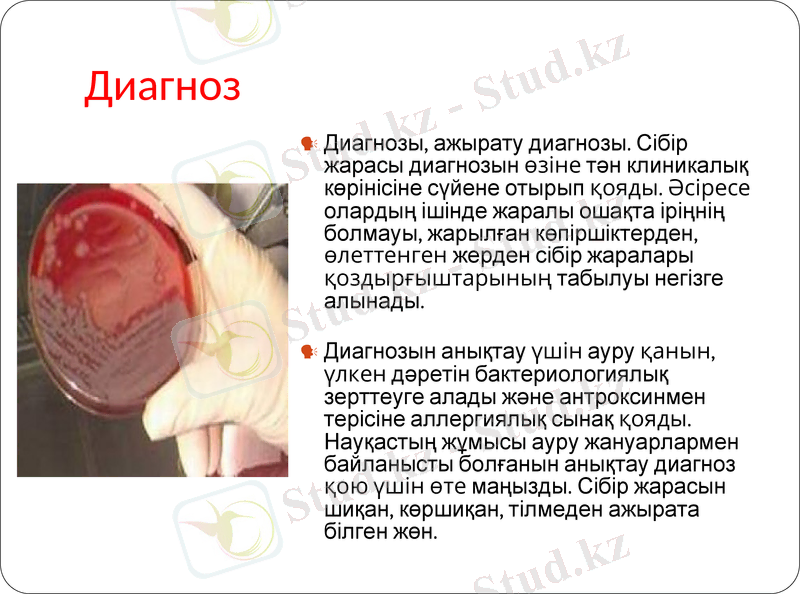
Slide 8

Сібір жарасының клиникасы, патогенезі, диагностикасы және емі



Сібір жарасының клиникасы, диагностикасы және емі.

Сібір жарасы Туралы
Анықтамасы. Bacillus anthracis қоздырғышымен шақырылатын, клиникасында терінің серозды геморрагиялық қабынуымен, лимфа түйіндерінің ұлғаюымен, қызба және интоксикациямен сипатталатын жедел бактериальды зоонозды инфекциялық ауру.

Этиологиясы
Қасиеті-қозғалмайтын, капсула түзетін грам оң таяқша (антифагоцитарлы әсері бар) . Сыртқы ортада спора түзеді. Экзотоксин бөледі, оның әсері:
тканьдік ісіну
тканьдік тыныс алу процесінің бұзылысы
фагоциттер белсенділігін тежейді.

Эпидемиологиясы
Инфекция көзі болып:
жиі ірі және ұсақ малдар, жылқы (60-85%)
сирек шошқа, түйе, есе, жабайы жануарлар

Берілу жолдары
контакты
алиментарлы
ауа-шаң арқылы
трансмиссивті

Патогенезі
Қоздырғыштың ену жолы:
зақымдалған тері
тыныс жолдары шырышты қабаты
асқазан ішек жолдарының шырышты қабаттары
қоздырғыш кірген жерінде және регионарлы лимфа түйіндерінде көбейеді
экзотоксин бөледі
жергілікті әсер (геморрагиялық-некротикалық қабыну)
жалпы әсері (токсемия) интоксикациялық синдром

Клиникалық көрінісі
Бет-жақ аймағында, әдетте сібір жарасының жергілікті шектелген (терілік) түрі дамиды. Ауру жәй, жалпы көріністері байқалмай дамуы мүмкін, бірақ дене қызуы 38°-қа дейін көтеріледі. Ауру басталар алдында бет терісінде қышитын түйіншек пайда болады. Оның ортасында қанды бөртік, ал айналасында үлкен инфильтрат дамып, жұмсақ тіндері домбығып ісінеді. Бөртік өздігінен жарылып, инфильтраттың бетінде қатты қара түсті қабыршақ пайда болады. Қабыршақтың айналасынан сарысу шығып тұрады. Инфильтрат айналасы білікті ісініп, түбі қарайған жара пайда болады. Жараның айналасындағы күлдіреген көпіршіктер жарылып 5-6 күннен кейін көршиқан дамиды. Төменгі жақасты, иекасты және мойын лимфа түйіндері үлкейіп, қатаяды. Сібір жарасы немесе көршиқан инфекциясының күшейіп асқынып, аурудың жағдайы нашарлап, дене қызуы 40°-қа дейін көтеріліп, организм улануының тағы да басқа көріністерімен си-патталады. Жара ауыз қуысының шырышты қабығына да шығуы мүмкін. Мұндай жағдайда инфильтрат айналасындағы жұмсақ тіндер қатты ісінеді. Жұтқыншақ ісінгенде аурудың тыныс алуы нашарлап, жұтынғанда ауырсынып, дауысы қарлығады.
Диагноз
Диагнозы, ажырату диагнозы. Сібір жарасы диагнозын өзіне тән клиникалық көрінісіне сүйене отырып қояды. Әсіресе олардың ішінде жаралы ошақта іріңнің болмауы, жарылған көпіршіктерден, өлеттенген жерден сібір жаралары қоздырғыштарының табылуы негізге алынады.
Диагнозын анықтау үшін ауру қанын, үлкен дәретін бактериологиялық зерттеуге алады және антроксинмен терісіне аллергиялық сынақ қояды. Науқастың жұмысы ауру жануарлармен байланысты болғанын анықтау диагноз қою үшін өте маңызды. Сібір жарасын шиқан, көршиқан, тілмеден ажырата білген жөн.

Сібір жарасынан өлген малдар

Емі
Сібір жарасы, көршиқан бетте, ауыз қуысының шырытшы қабығында орналасса консервативті ем қолданады. Ауруға емдік майлы танбалар қолданып, тыныштық жағдай туғызады. Дезинтоксикациялық, десенсибилизациялық, жалпы денсаулығын нығайту терапиясын жүргізеді, антибиотиктер мен сульфаниламидтер тағайындайды. Сібір жарасының ағымы ауыр, инфекция күшейіп жайылған жағдайда пенициллиңді 1, 5-2 миллионнан, стрептомицинді тәулігіне 6-8 рет организмге ендіреді. Антибиотиктерді ауыстырғанда тетрациклин, левомицитин, цефалоспорин, макролид т, б. дәрілерді қолданған жөн.

Асқынулары
инфекциялық-токсикалық шок
өкпе ісігімен бірге жедел тыныс жетіспешілігі
ми ісінуі
Диагностикасы
сібір жарасының диагностикасы клинико-эпидемиоллгиялық және лабораторлы мәліметтер негізінде қойылады.
бактериологиялық әдіс (карбункул, қан, қақырық, фекалий (нәжістен) жағынды
иммунофлюоресценция әдісі
аллергиялық әдіс (антроксинмен бірге терілік аллергиялық проба)
Салыстырмалы диагностикасыу
оба ауруының терілік формасымен
туляремия
фурункул, тілме
пневмония
дизентерия
жедел панкреатит

Алдын алу
Ауыл шаруашылығындағы малдар мен адамдарға сібір жарасымен аурудың алдын алуы үшін медико-ветеринарлы комплексте шаралар жүргізу.
арнайы спецификалық алдын алу (қауіпті топтарға және эпид. көрсеткіштері барларға-тірі вакцина қолдану), иммуниза тері астына немее тері астына немесе тері үстіне қойылады, 2 рет 21 күннен.

Емі
Емі комплексті
этиотропты препараттар (пенициллин, тетрациклин, доксациклин, гентамицин, цефалоспориндер) 7-8 күн ішінде
сібір жарасына қарсы иммуноглобулин
патогенетикалық және симптоматикалық ем
Соңы
жақсы (көбінесе терілік формасында)
өлім (көбінесе септикалық формасында)
Диспансеризация
Сібір жарасымен ауырған науқастар диспансеризацияға жатпайды. Сібір жарасы ошағынлағы эпидемияға қарсы әдістер:
науқасты жекешеленджіру (госпитализация)
дезинфекция
Науқастың қарымқатынаста болған адамдарға экстенді алдын алу жүргізіледі (антибиотикалық сібір жарасына қарсы иммуноглобулин)

НАЗАРЛАРЫҢЫЗҒА РАҚМЕТ!!!
- Іс жүргізу
- Автоматтандыру, Техника
- Алғашқы әскери дайындық
- Астрономия
- Ауыл шаруашылығы
- Банк ісі
- Бизнесті бағалау
- Биология
- Бухгалтерлік іс
- Валеология
- Ветеринария
- География
- Геология, Геофизика, Геодезия
- Дін
- Ет, сүт, шарап өнімдері
- Жалпы тарих
- Жер кадастрі, Жылжымайтын мүлік
- Журналистика
- Информатика
- Кеден ісі
- Маркетинг
- Математика, Геометрия
- Медицина
- Мемлекеттік басқару
- Менеджмент
- Мұнай, Газ
- Мұрағат ісі
- Мәдениеттану
- ОБЖ (Основы безопасности жизнедеятельности)
- Педагогика
- Полиграфия
- Психология
- Салық
- Саясаттану
- Сақтандыру
- Сертификаттау, стандарттау
- Социология, Демография
- Спорт
- Статистика
- Тілтану, Филология
- Тарихи тұлғалар
- Тау-кен ісі
- Транспорт
- Туризм
- Физика
- Философия
- Халықаралық қатынастар
- Химия
- Экология, Қоршаған ортаны қорғау
- Экономика
- Экономикалық география
- Электротехника
- Қазақстан тарихы
- Қаржы
- Құрылыс
- Құқық, Криминалистика
- Әдебиет
- Өнер, музыка
- Өнеркәсіп, Өндіріс
Қазақ тілінде жазылған рефераттар, курстық жұмыстар, дипломдық жұмыстар бойынша біздің қор #1 болып табылады.



Ақпарат
Қосымша
Email: info@stud.kz